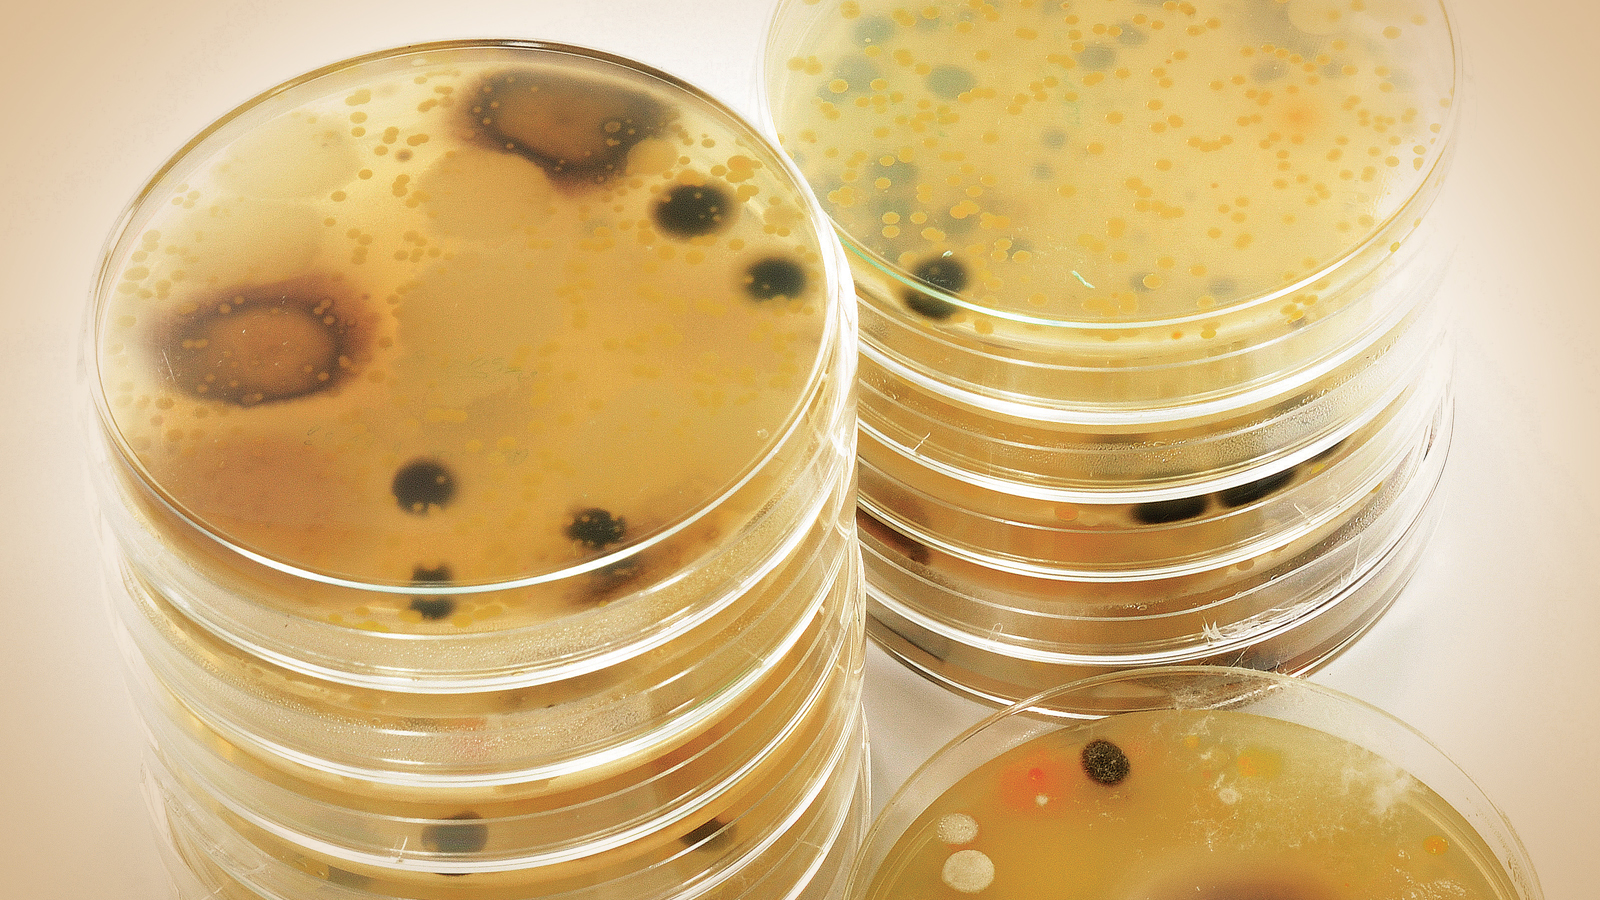

“Başarımızın sırrı doğru seçimler”
Sağlıklı nesiller “Çiftlikten Çatala” yaklaşımı ile dünyamız için; kaynakların etkin kullanımı adına verimli üretim vizyonuna sahip Gedik Piliç, 7 yıldır Hemicell kullanıyor. Gedik Piliç Yem Fabrikası Müdürü Eda Akyüz, Hemicell deneyimini bizlerle paylaştı.